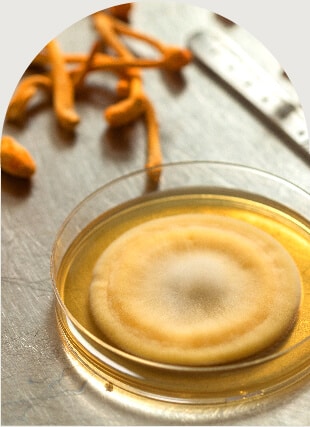
קורדיספס

בואו נדבר על מחזור החיים של פטריות
פטריות הן ממלכה של אורגניזם בפני עצמו. בעבר הפטריות סווגו כצמחים אך למעשה הן לא צמחים ולא חיות. בניגוד לצמחים המתרבים בעזרת זרעים, הפטריות מתרבות בעזרת נבגים ואינן מבצעות פוטוסינתזה. התפקיד העיקרי של פטריות בטבע הוא פירוק חומר אורגני.
נבג: הנבג נקלט באדמה ומתפתח לרשת קורים, הנקראת תפטיר.
תפטיר: רשת התפטיר גדלה על חומר אורגני – שהיא בעצם הפטרייה עצמה.
גוף הפרי: החלק המוכר ביותר של הפטרייה הוא גוף הפרי המופיע מעל פני הקרקע לזמן קצר.
כשהפטרייה מגיעה לבגרות ומשלימה את מחזור חייה, היא מפיצה מיליוני נבגים שנעים באוויר וכך היא מתרבה.
גופי פרי
החלק המוכר ביותר של הפטרייה הוא גוף הפרי המופיע מעל הקרקע לזמן קצר.
תפטיר
רשת התפטיר גדלה על חומר אורגני – שהוא למעשה הפטרייה עצמה.
נבגי הפטרייה
הנבגים נספגים באדמה ומתפתחים לרשת של קורים, הנקראת תפטיר. כאשר הפטרייה מגיעה לבגרות ומסיימת את מחזור חייה, היא מפזרת מיליוני נבגים שנעים באוויר וכך היא מתרבה.
גופי פרי
תפטיר
נבגי הפטרייה
Mushroom have several growth stages
1
Mushrooms begin their growth stage when the spore germinates. A germinating spore must mate with a compatible spore type to advance to the next stage of growth.
2
The second is the mycelial stage. Mycelium must survive and thrive in very competitive environments.
3
The final stage is the fruit body that produces and releases the spore for the next generation of mushrooms. Fruit bodies generally last for only a few days in most mushroom species.
Whole Mushroom
Each stage has its own benefits, and that’s why Om uses the whole mushroom, including both the mycelium and the fruiting body.
תהליך הגידול שלנו
1
פיתוח ושימור תרביות
אנו מפתחים ומשביחים תרביות ייחודיות בעלות פוטנציאל מקסימלי. עבודת המחקר והפיתוח היא מרכזית בעשיה שלנו, ומאפשרת להמשיך לפתח תרביות חדשות ומשופרות לאורך הזמן.

2
קטיף
זמן הקטיף של גוף הפרי הנו משמעותי ביותר, על מנת לשמור על איכות הפטרייה הגבוהה ועל כמות החומרים הפעילים שהיא מכילה. את גופי הרבייה יש לקצור בזמן מדויק ביותר, ומדובר בחלון הזדמנויות של מספר ימים בודדים בלבד! תהליך הקטיף מתבצע בצורה סטרילית ונקיה במקביל לבקרת איכות מקסימלית.

3
ייבוש
ייבוש גוף הפרי של הפטרייה מתבצע באמצעות מכונות יחודיות לייבוש בהקפאה, על מנת לשמור על מירב החומרים הפעילים ולמזער פגיעה בהם ככל שאפשר.
בקרת איכות
אנו במיקוספרינג מתחייבים לאיכות הטובה ביותר, ומבצעים בדיקות קפדניות מעת לעת על מנת לשלול הימצאות של כימיקלים וחומרים אשר עלולים לפגוע באיכות, ולהבטיח מוצר איכותי, בטוח לצריכה ויעיל באופן מקסימלי לשיפור איכות החיים.












